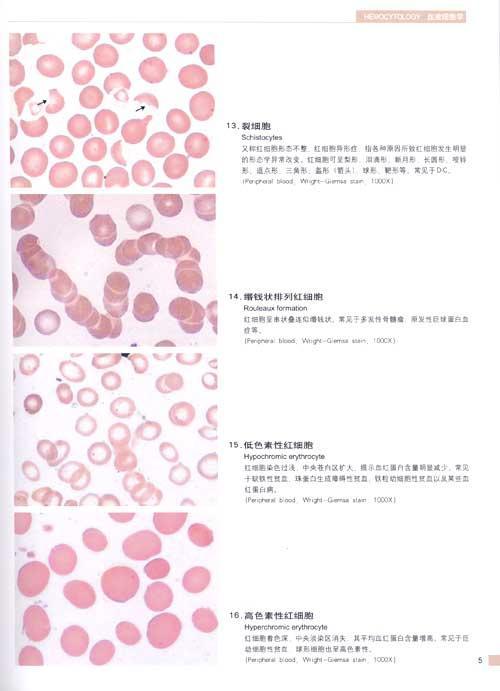
嗜多色性红细胞 11.泪滴形红

泪滴状红细胞

泪滴状红细胞
图片尺寸304x285
泪滴状红细胞
图片尺寸200x133
请报告箭头所指细胞的名称
图片尺寸854x640
宣传推广
图片尺寸1080x818
a.泪滴形红细胞 b.裂红细胞 c.棘形红细胞 d.口形红细胞 e.靶形红细胞
图片尺寸279x268
泪滴样红细胞外形不规则,有2至3个尖角呈盔形,多见于弥散性血管内凝血
图片尺寸356x258
第一节 概述 第二节 血液实验室检查ppt 成熟红细胞形如泪滴样或梨
图片尺寸1080x810
见原始细胞,幼稚粒细胞,有核红细胞及泪滴形红细胞,建议做nap积分
图片尺寸824x704
图 7心脏机械瓣膜破坏产生的破碎红细胞注:机械瓣与溶血破坏相比,特点
图片尺寸360x232
请点击查看答案▼答案:泪滴形红细胞【温故而知新】泪滴形红细胞,红
图片尺寸1080x821
于肝病,脾切除,无p脂蛋白血症; 泪滴状红细胞常见于骨髓纤维化
图片尺寸614x407
其它 血液检测 写美篇泪滴状红细胞
图片尺寸1584x876
外伤,化学毒素多沉淀.泪滴状
图片尺寸1604x1200
图7 正常红细胞形态
图片尺寸220x137
红细胞|淋巴细胞|粒细胞|血小板_网易订阅
图片尺寸660x478
泪滴形红细胞: 红细胞形态不整(rdw升高):最常见于巨幼贫.
图片尺寸247x199
一滴血检测教程
图片尺寸960x723
珠蛋白生成障碍性贫血时,外周血红细胞主要是泪滴形
图片尺寸594x410
嗜多色性红细胞 11.泪滴形红
图片尺寸500x691
见原始细胞,幼稚粒细胞,有核红细胞及泪滴形红细胞,建议做nap积分
图片尺寸721x803